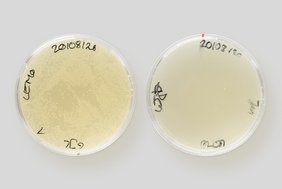

Immer mehr bakterielle Krankheitserreger sind gegen Antibiotika resistent. Dabei haben die gefährlichsten Keime eines gemeinsam: Sie verfügen über eine doppelte Membran, die schwer zu durchdringen ist. Und selbst wenn antibiotische Wirkstoffe diese Hülle knacken, werden sie von den Bakterien meist gleich wieder hinausgepumpt. Doch dem kürzlich entdeckten Darobactin gelingt es, diese Schutzvorkehrungen zu umgehen und fast alle Problemkeime zu töten. Den Wirkmechanismus dahinter konnten Forschende nun in einem vom Schweizerischen Nationalfonds (SNF) finanzierten Projekt des Nationalen Forschungsprogramms "Antimikrobielle Resistenz" (NFP 72) aufklären.
Wie ein abgebrochener Schlüssel
In einer jetzt in Nature* veröffentlichten Studie beschreiben sie, wie ein Täuschungsmanöver den Erfolg von Darobactin ermöglicht: Es imitiert mit seiner Form eine besondere dreidimensionale Struktur, die sonst nur diejenigen Proteine besitzen, welche von Bakterien als Bausteine für ihre äussere Membran selbst produziert werden. Die besagte Struktur ist der Schlüssel, um die Proteine an bestimmten Orten von innen her in die äussere Hülle einzupassen. Darobactin ist eine Kopie dieses Schlüssels. Doch es nutzt dies nicht, um in die Bakterien einzudringen, sondern blockiert lediglich das Schlüsselloch von aussen. So, als würde man eine Tür abschliessen und dann den Schlüssel abbrechen. Die Folge: Den Bakterien ist der Transportweg für ihre Hüllenbausteine versperrt und sie sterben.
Mit üblichen Methoden kaum erkennbar
Verwandte Mechanismen sind in der Mikrobiologie bereits bekannt und werden durch andere Medikamente verwendet. Die dabei anvisierten Bindestrukturen, oder eben Schlüssellöcher, sind in der Regel recht gross – zumindest für mikrobiologische Verhältnisse. Im Gegensatz dazu ist das von Darobactin genutzte Ziel sehr klein und mit üblichen Methoden gar nicht erkennbar. Dies, obwohl Darobactin grösser ist als die meisten Wirkstoffe und nicht einmal durch die Eintrittspforten der Bakterien passen würde.
"Das hat uns am Anfang vor Rätsel gestellt", sagen Sebastian Hiller und Timm Maier vom Biozentrum der Universität Basel, die zwei Hauptautoren der nun vorgelegten Studie. Zwar hätten sie und ihre Teams sofort erkannt, dass Darobactin nicht im Inneren der Erreger wirkt, sondern auf deren Oberfläche. Dort nämlich stört es die Funktion des Proteins BamA, das beim Aufbau der doppelten Schutzmembran eine zentrale Rolle einnimmt. "Doch wie genau Darobactin mit BamA interagiert, war völlig unklar", so Hiller. Erst durch die Kombination von mehreren Methoden kamen die Forschenden dem Vorgang schliesslich auf die Spur.
Perfekte Schwachstelle erwischt
Dabei erkannten sie, dass Darobactin eine wahre Achillesferse der Erreger angreift: Es bindet direkt an die wichtigsten, sogenannten "Rückgrat"-Atome von BamA. Weil diese Atome das Protein zusammenhalten und seine Form vorgeben, können sie kaum verändert werden – doch genau dies wäre für Bakterien der einfachste Weg, um auch Darobactin in absehbarer Zeit abzuwehren. Tatsächlich behielt Darobactin jedoch seine Wirksamkeit gegen alle Erreger, für die Hiller und sein Team Labortests durchführten, mit denen man Resistenzen künstlich erzeugen kann. Wiederum im übertragenen Sinn gesagt: Es gelang den Erregern nicht, das "geknackte" Schloss auszuwechseln.
Gezielte Entwicklung von Medikamenten
Für eine mögliche Anwendung in der Medizin seien diese Erkenntnisse ein entscheidender Schritt, sagt Infektionsbiologe Dirk Bumann, der ebenfalls am Biozentrum Basel forscht. Als Ko-Direktor des wie das NFP 72 vom SNF finanzierten Nationalen Forschungsschwerpunkts AntiResist verfolgt er das aktuelle Geschehen in der Antibiotikaforschung eng. "Die Aufschlüsselung des Wirkmechanismus von Darobactin ist ein grosser Erfolg", sagt er, "denn das ermöglicht es, Darobactin gezielt zu verbessern und zu einem wirksamen Medikament zu entwickeln". Die langehegte Hoffnung auf eine neue Generation Antibiotika, die gegen viele der heutigen Problemkeime eingesetzt werden kann, erhält damit starken Auftrieb.
SNF
Originalpublikation:
H. Kaur et al.: The antibiotic darobactin mimics a ß-strand to inhibit outer membrane insertase. Nature (2021). Doi 10.1038/s41586-021-03455-w